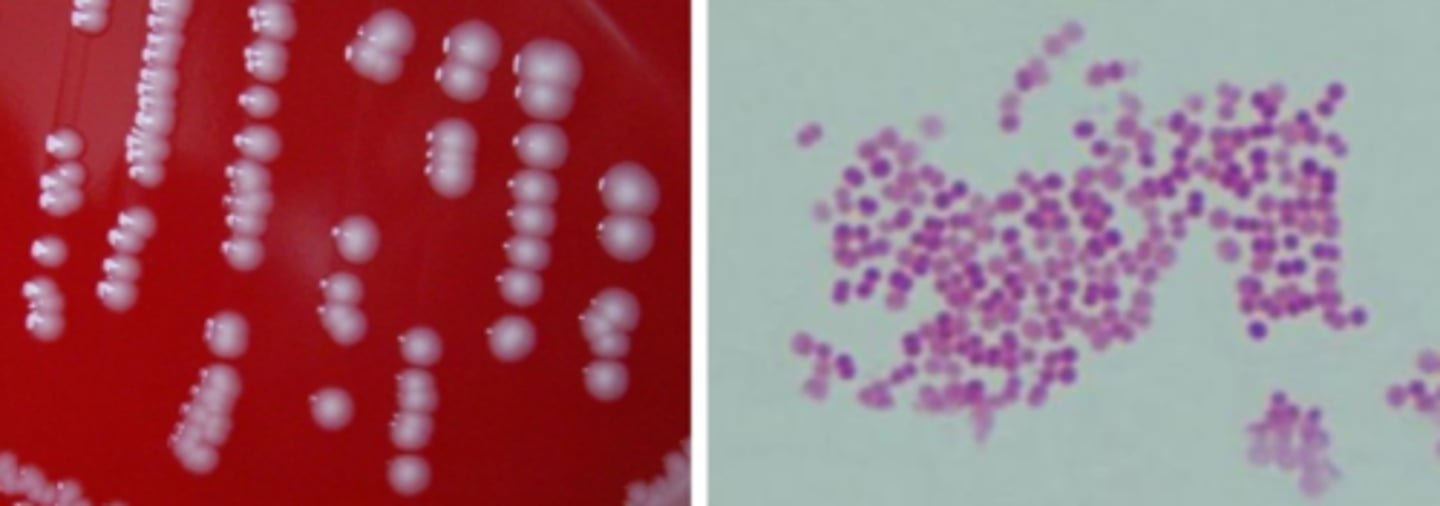
<p>-Growth on blood, chocolate</p><p>-Does NOT grow on MacConkey</p><p>-Colony moves like hockey puck</p>
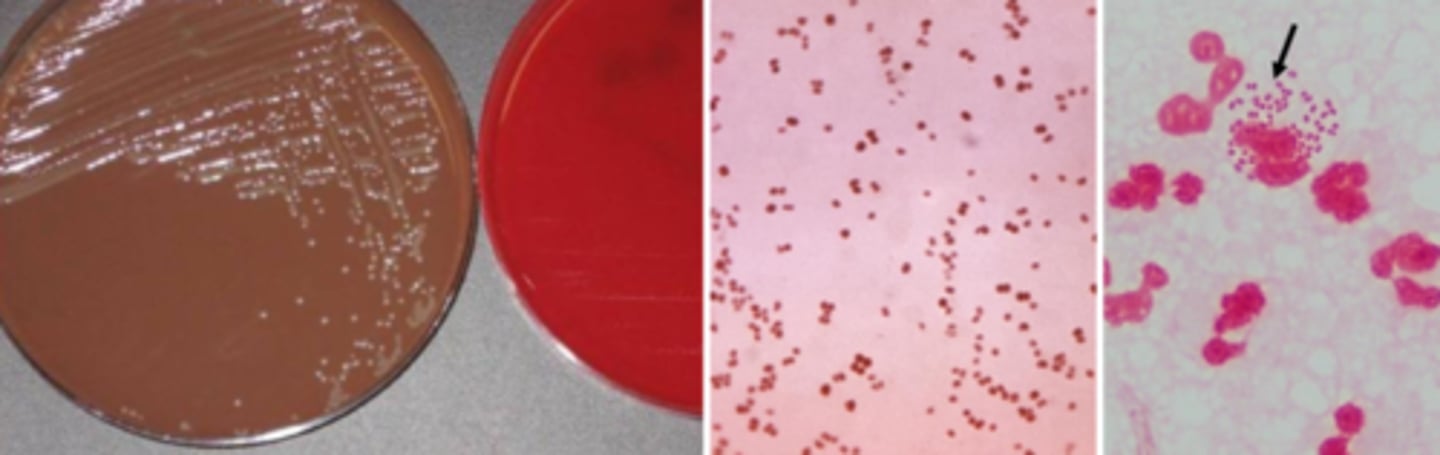
<p>-Grows on chocolate</p><p>-Grows on Thayer Martin</p><p>-Does NOT grow on blood</p><p>-Intracellular (neutrophil) -gram negative diplococci (GNDC), male swab in urethra and identify right away</p>
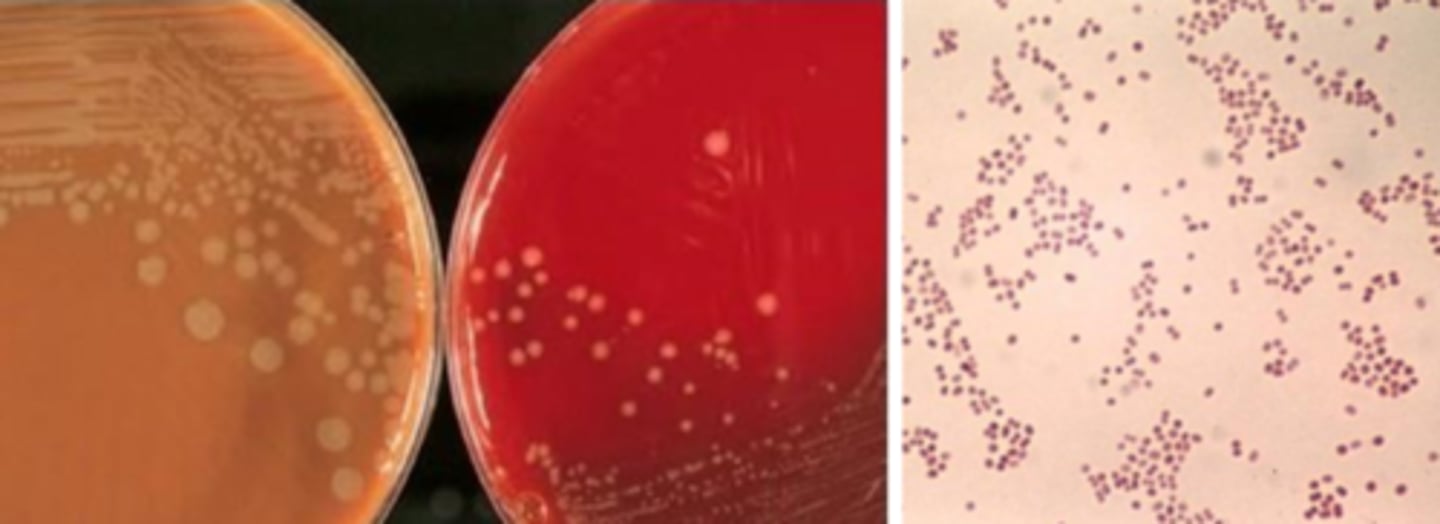
<p>Growth on blood, chocolate, Thayer Martin</p>
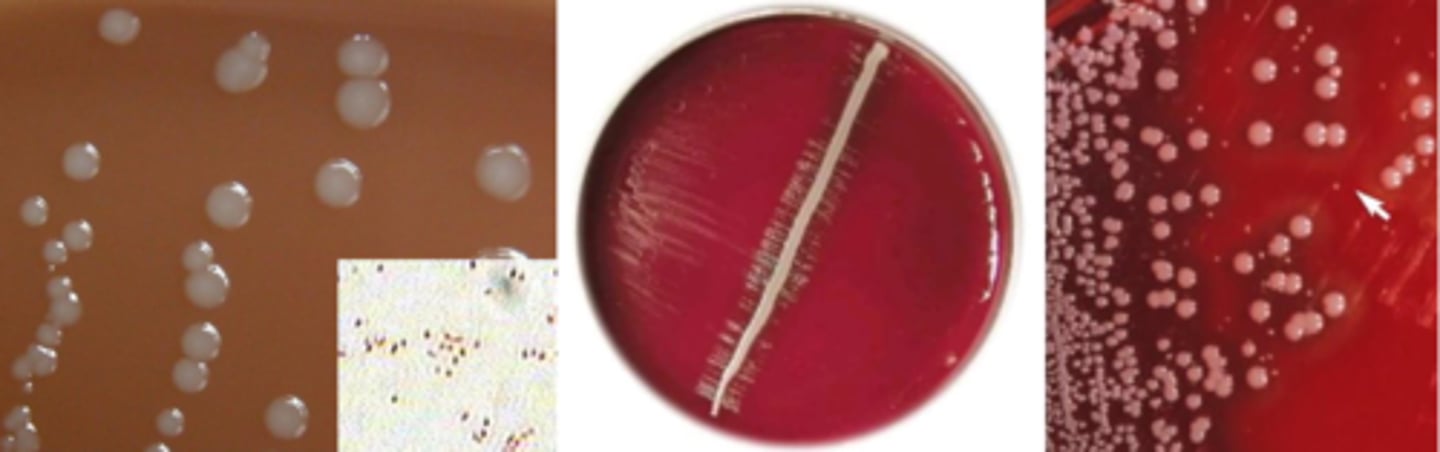
<p>-Growth on chocolate</p><p>-No growth on blood or MacConkey</p><p>-Can satellite around staphylococci to grow on blood</p>
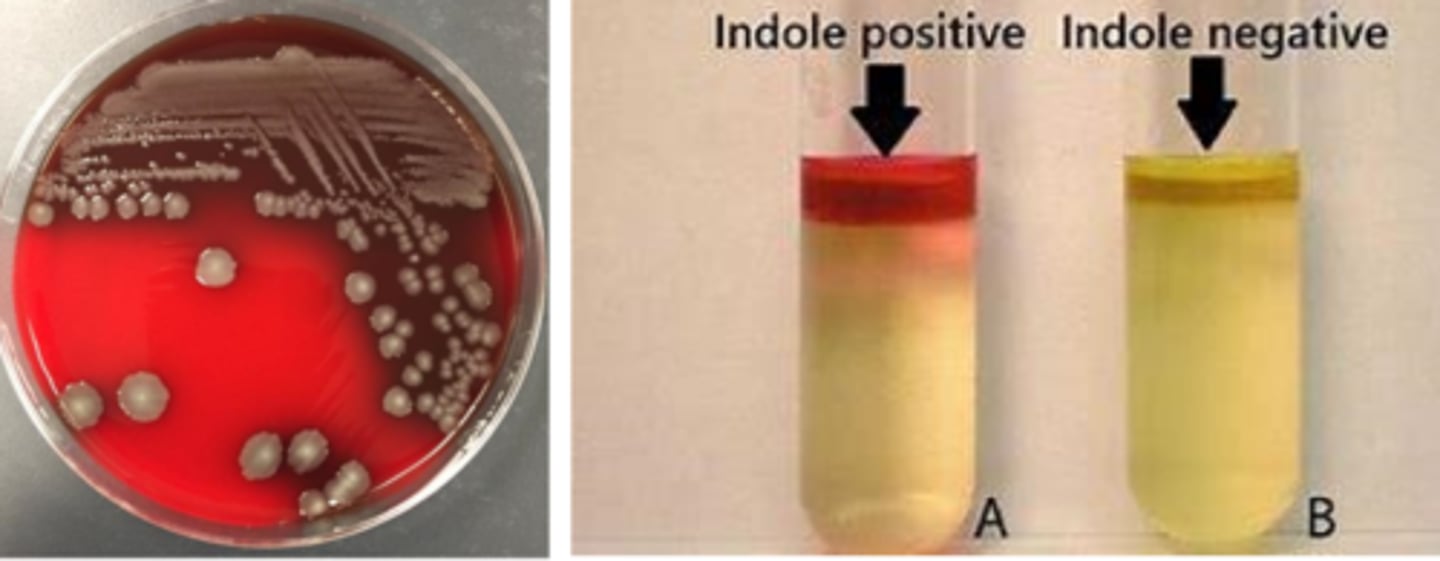
<p>Lactose fermentation</p><p>Voges Proskauer negative</p><p>Many beta- hemolytic</p><p>Indole positive</p>
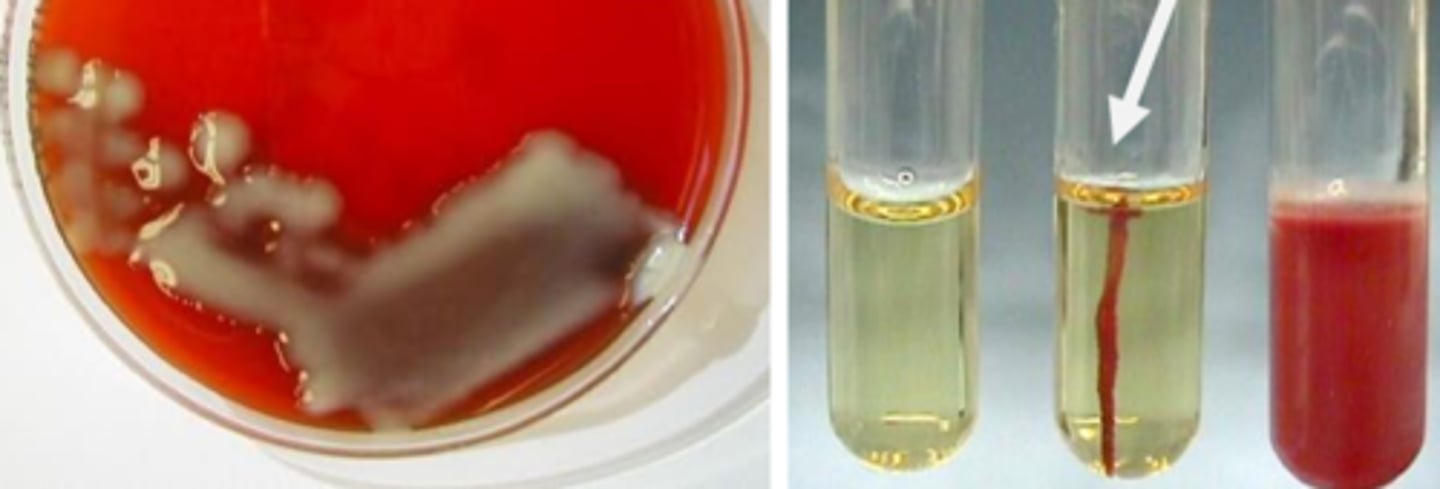
<p>Lactose fermentation</p><p>Vogues Proskauer positive</p><p>Nonmotile</p><p>Capsule</p><p>Ornithine-negative</p>
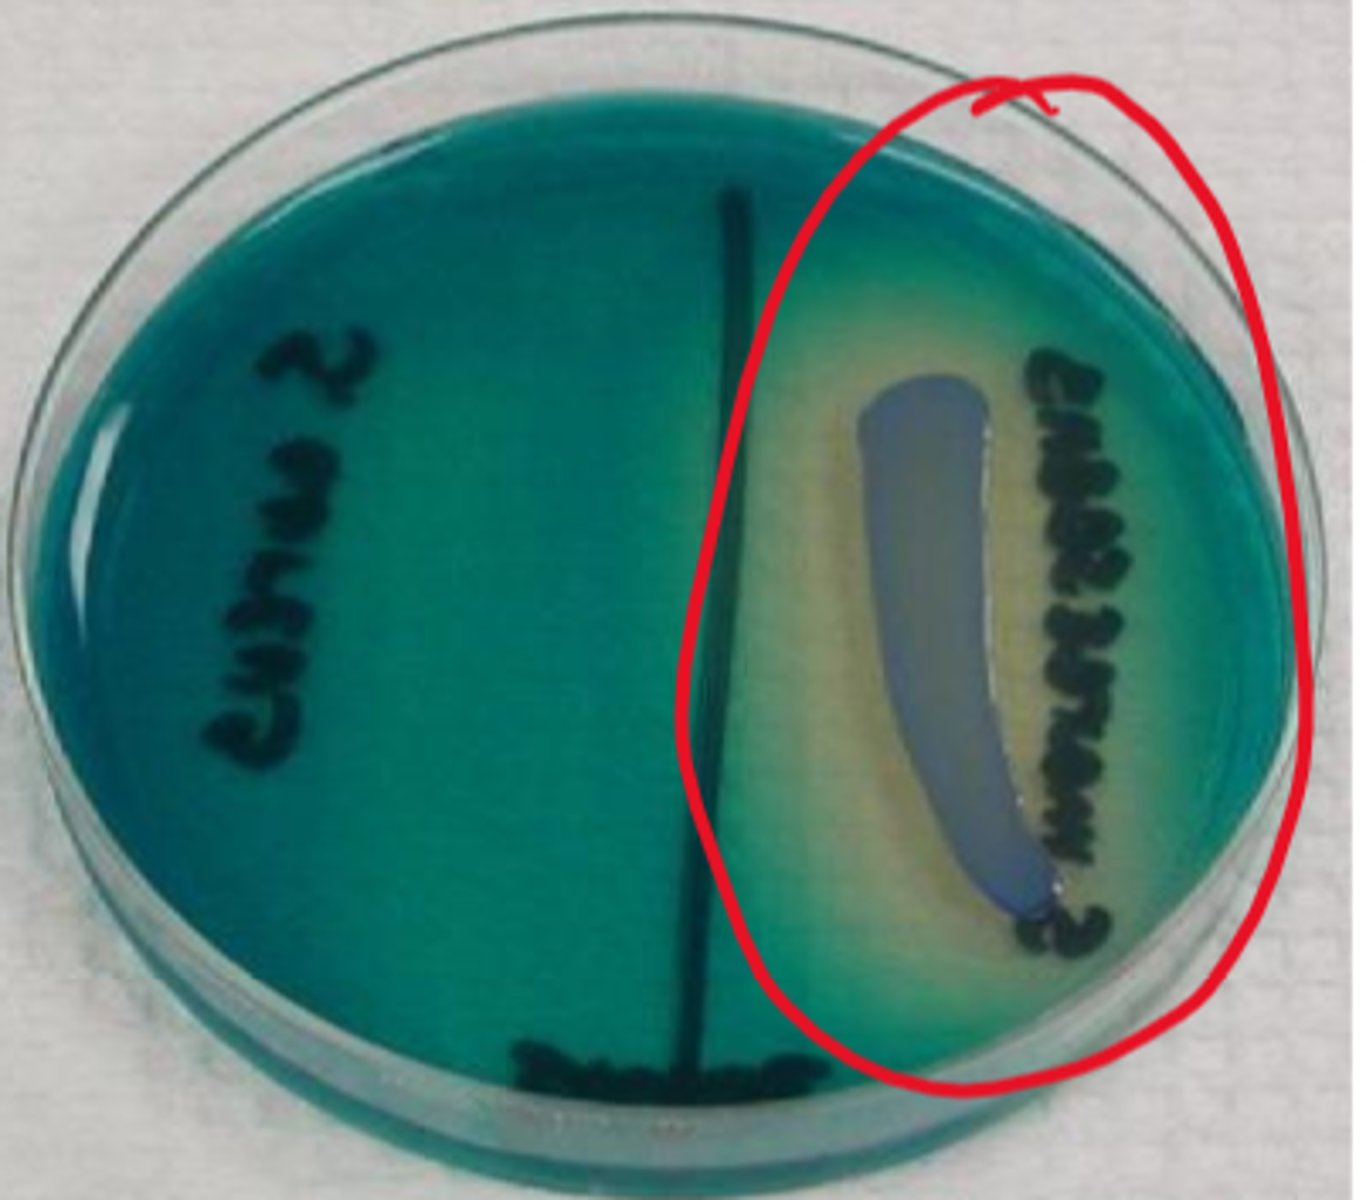
<p>Citrate only C source</p><p>Gelatin hydrolysis</p><p>DNAse positive</p>
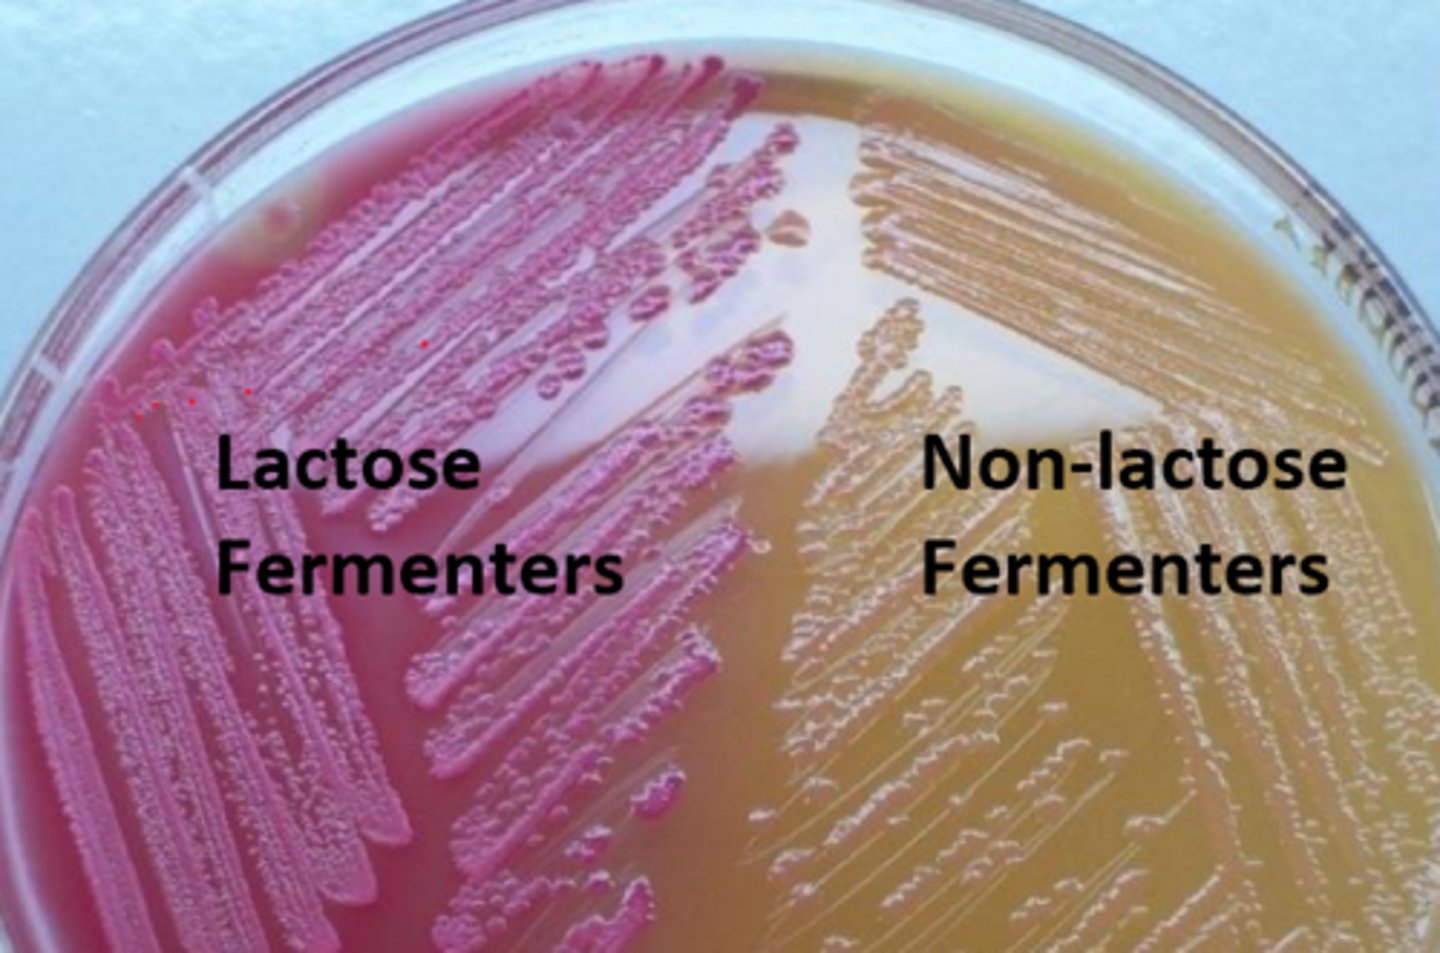
<p>Escherichia</p><p>Klebsiella</p><p>Enterobacter </p>
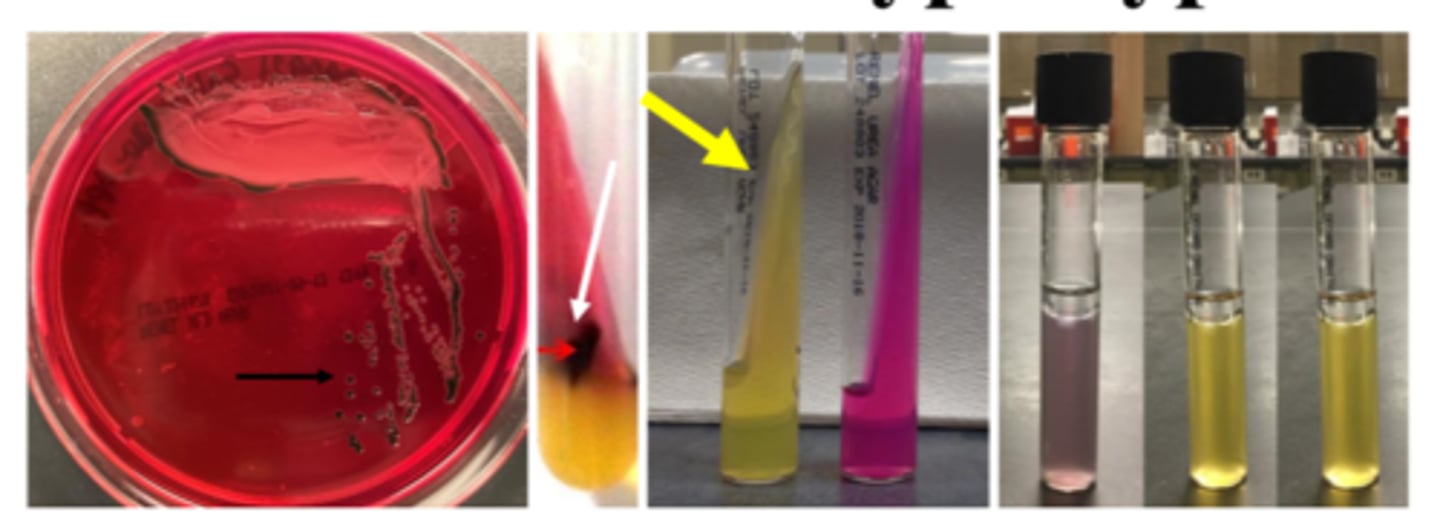
<p>-Non-lactose fermentation</p><p>-Growth on highly selective agar</p><p>-H2S-positive (crescent ring)</p><p>-Urease-negative</p><p>-Phenylalanine-negative</p><p>-can decarboxylate lysine (NOT arginine or ornithine)</p><p>-typhoid fever</p><p>-motile</p>
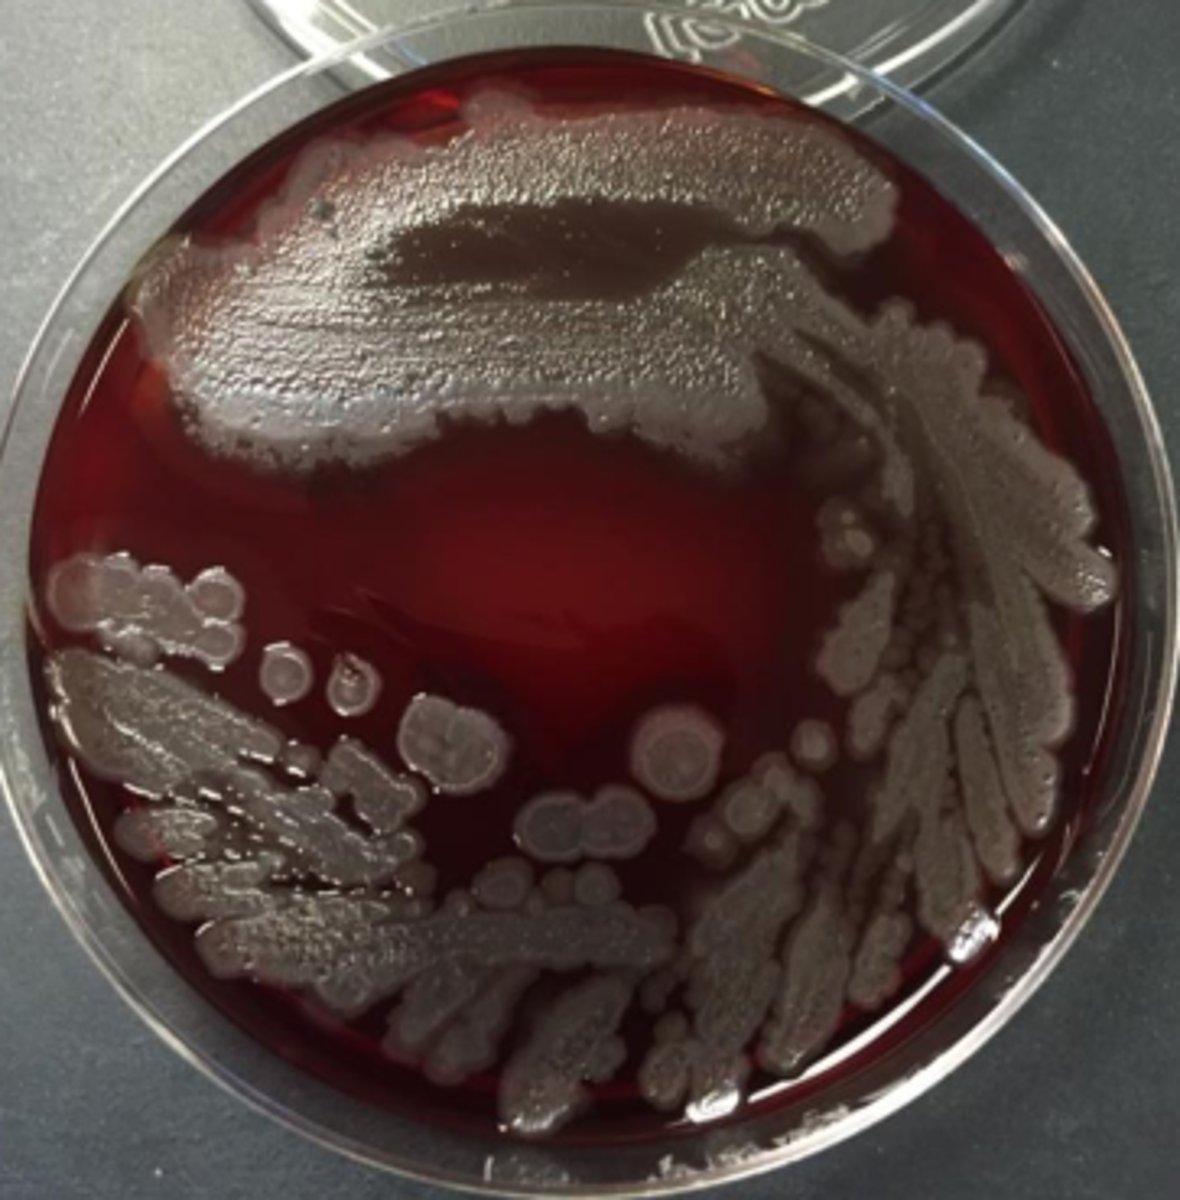
<p>Can be B-hemolytic</p><p>Can be mucoid</p><p>Can be metallic</p><p>Grow on blood, chocolate, MacConkey</p><p>Grape Kool-Aid odor</p><p>Maybe corn tortilla chips</p>
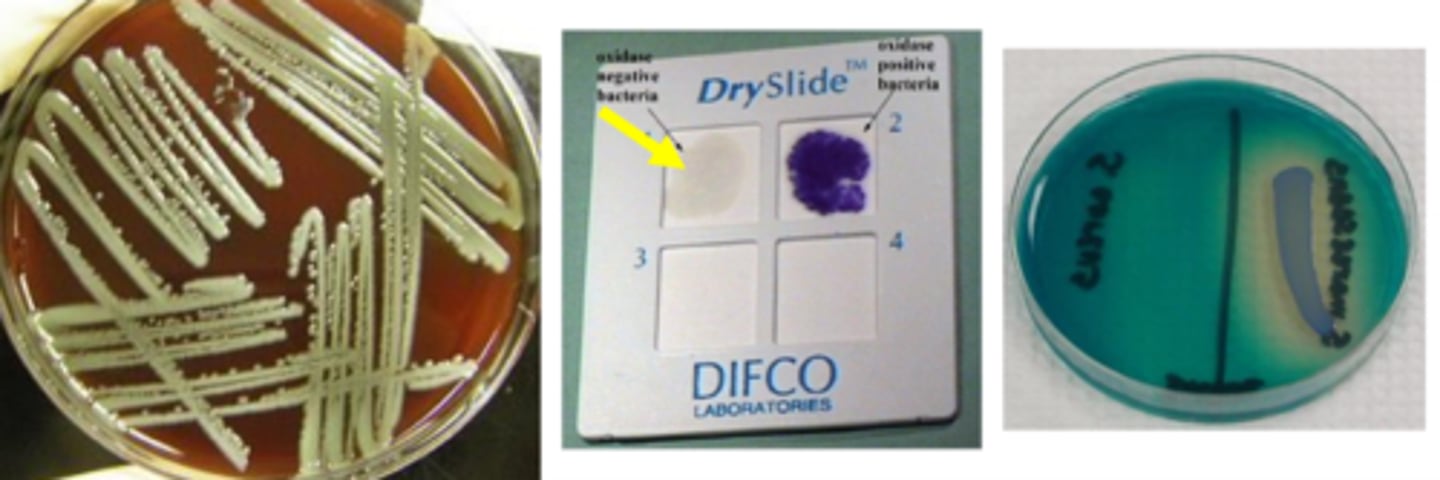
<p>Yellow pigment</p><p>Grow on blood, chocolate, MacConkey</p><p>Odor - grandma's basement</p>
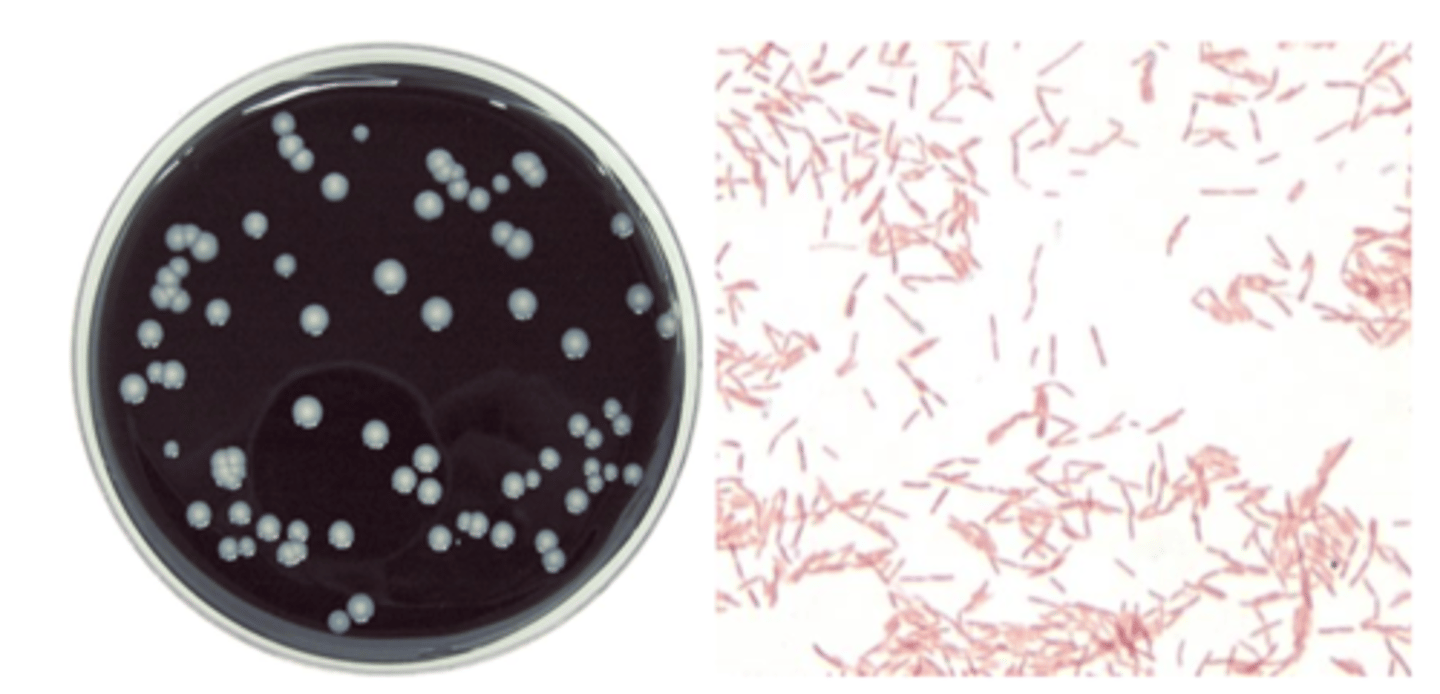
<p>Specimen treatment to reduce contaminants</p><p>Growth on Buffered Charcoal Yeast Extract (BCYE)</p><p>No growth on blood</p><p>Carbolfuchsin counterstain</p><p>We’re bad at growing this</p>

1/92
Looks like no tags are added yet.
Name | Mastery | Learn | Test | Matching | Spaced | Call with Kai |
|---|
No study sessions yet.
Moraxella catarrhalis reservoir
upper respiratory tract
high colonization rates in children
Moraxella catarrhalis virulence
disease strains have greater b-lactamase production than commensals
Able to "survive" b-lactam Rx for other upper respiratory pathogens
Moraxella catarrhalis diseases
lower respiratory tract
otitis media
sinusitis
ocular infections
Moraxella catarrhalis growth/screens
-Growth on blood, chocolate
-Does NOT grow on MacConkey
-Colony moves like hockey puck
Moraxella catarrhalis identification
Oxidase positive
Catalase positive
b-lactamase positive
butyrate esterase positive
doesn't eat sugar
Neisseria gonorrhoeae reservoir
Humans are only reservoir
(Mucosa of urethra, cervix, rectum, pharynx, eyes)
Neisseria gonorrhoeae virulence
Lipooligosaccharide (LOS) antigenic variation increases adherance and decreases humoral immunity
pili and opacity proteins modulate attachment
Neisseria gonorrhoeae diseases
Gonorrhea (urethritis, cervicitis, disseminated)
Complications of epididymitis and pelvic inflammatory disease
Ophthalmia neonatorum (eyes in newborns)
Rectal, pharyngeal infection often asymptomatic
Neisseria gonorrhoeae growth/screens
-Grows on chocolate
-Grows on Thayer Martin
-Does NOT grow on blood
-Intracellular (neutrophil) -gram negative diplococci (GNDC), male swab in urethra and identify right away
Neisseria gonorrhoeae identification
Oxidase positive
Catalase positive
Gamma-glutamyl-aminopeptidase-negative
Glucose positive
Neisseria meningitidis reservoir
Humans are only reservoir
Normal flora and pathogen
Neisseria meningitidis virulence
Droplet secretions (repeated close contact)
Anti-phagocytic capsule (13+ types)
Neisseria meningitidis diseases
Invasive disease: meningitis, acute sepsis (high mortality having both)
Complement deficiency, asplenia risk factors
Sequelae may occur
Rare: pneumonia, septic arthritis
Neisseria meningitidis growth/screens
Growth on blood, chocolate, Thayer Martin
Neisseria meningitidis identification
Oxidase positive
Catalase positive
Gamma-glutamyl-aminopeptidase positive
Glucose positive
Maltose positive
gram negative diplococci
Moraxella catarrhalis
Neisseria gonorrhoeae
Neisseria meningitidis
Haemophilus influenzae reservoir
Commensal in mucous membrane (upper RT)
Non-typeable: colonize 90% of people
Type B: colonization has been reduced (type based on capsule)
Haemophilus influenzae virulence
-Antecedent virus infection causes inflammation and damage to mucosa
-Enters bloodstream
-Type B capsule is resistant to phagocytosis
Haemophilus influenzae diseases
Invasive: bacteremia, meningitis, epiglottis due to Type B
Nontypeable: conjunctivitis, otitis media, pneumonia, acute exacerbation of chronic bronchitis (often secondary to a viral infection)
Haemophilus influenzae growth/screens
-Growth on chocolate
-No growth on blood or MacConkey
-Can satellite around staphylococci to grow on blood
Haemophilus influenzae identification
X and V growth requirement
Negative porphyrin test
Gardnerella vaginalis reservoir
Anorectal microbiome of both genders
Normal vaginal flora in women of reproductive age
Loves pH between 6-7
Gardnerella vaginalis diseases
Bacterial vaginosis: cascade of events relative to lactobacillus depletion
Can complicate pregnancy: chorioamnionitis, premature rupture of membranes, pre-term birth
Gardnerella vaginalis growth/screens
-very tiny on blood agar
-Gram-negative (variable) coccobacilli
-Hippurate hydrolysis

Gardnerella vaginalis identification
Be careful on culture:
Should not use culture to identify bacterial vaginosis
Clue cells
Molecular diagnostics
Pasteurella reservoir
P. multocida: nasopharynx and gingiva of cats
P. canis: nasopharynx and gingiva of dogs

Pasteurella diseases
Bite wound infections very rapid spread of erythema and/or inflammation
Less common: pneumonia or systemic disease
Pasteurella growth/screens
-Growth on blood and chocolate
-No growth MacConkey
-Can satellite around staphylococci

Pasteurella identification
Oxidase-negative
"sick TSI"
Penicillin susceptibility

Gram negative coccobacilli
Haemophilus influenzae
Gardnerella vaginalis
Pasteurella
Enteric gram-negative bacilli virulence
Endotoxin (LPS)
Adhesion, invasion molecules
Many with urease production
ESBL: extended-spectrum b-lactamase
CRE: carbapenem-resistant Enterobacterales
SPICE bugs: inducible AmpC B-lactamase
Enteric gram-negative bacilli diseases
-UTIs
-Intra-abdominal infections
-Skin and soft tissue infections
-Pneumonia
-Bloodstream infections
-Gastroenteritis
Enteric gram-negative bacilli therapy
Most drug classes with activity
NOT:
Macrolides
Vancomycin
Clindamycin
Penicillin
Metronidazole
Enteric gram-negative bacilli identification/characteristics
-Gram negative
-Ferment glucose
-Facultative
-Growth on routine media
-Non-spore forming bacilli
-Reduce nitrate to nitrites
-Oxidase negative
Enteric gram-negative bacilli
Escherichia coli
Klebsiella
Proteus
Serratia
Providencia
Morganella
Citrobacter
Enterobacter
Escherichia coli characteristics
Lactose fermentation
Voges Proskauer negative
Many beta- hemolytic
Indole positive
Klebsiella characteristics
Lactose fermentation
Vogues Proskauer positive
Nonmotile
Capsule
Ornithine-negative
Proteus characteristics
No lactose fermentation
Phenylalanine-positive
May swarm
H2S positive
Urease positive

Serratia characteristics
Citrate only C source
Gelatin hydrolysis
DNAse positive
Providencia characteristics
No lactose fermentation
Phenylalanine-positive
Citrate positive
H2S negative

Morganella characteristics
No lactose fermentation
Phenylalanine-positive
Indole-positive
Citrate negative
H2S negative

Citrobacter characteristics
Late lactose fermentation
Citrate sole carbon source
Indole or H2S; Odor

Enterobacter characteristics
Lactose fermentation
Oxidase negative
Vogues Proskauer-positive
Cefazolin resistant
Ornithine-positive
Motile

Enterobacterales that are lactose fermenters
Escherichia
Klebsiella
Enterobacter
Enterobacterales that are non-lactose fermentative
Citrobacter
Serratia
Proteus
Providencia
Morganella

non-typhoidal salmonella characteristics
-Non-lactose fermentation
-Growth on highly selective agar
-H2S-positive (black colonies)
-Urease-negative
-Phenylalanine-negative
-Can decarboxylate lysine, arginine, and ornithine
-Co #1 bacterial pathogen
-motile

salmonella serotype typhi characteristics
-Non-lactose fermentation
-Growth on highly selective agar
-H2S-positive (crescent ring)
-Urease-negative
-Phenylalanine-negative
-can decarboxylate lysine (NOT arginine or ornithine)
-typhoid fever
-motile
shigella characteristics
-Non-lactose fermentation
-Growth on selective agar
-H2S-negative
-Urease-negative
-non-motile
-#3 bacterial GI pathogen
-transmission: fomites, fingers, fleas, feces

campylobacter jejuni
-Oxidase-positive
-Microaerophilic (5% O2)
-Hippurate-positive
-42°C (warmer than body temp)
-Selective medium
-found in poorly stored food
-gull-winged bacilli
-watery colonies
-Co #1 bacterial GI pathogen

vibrio characteristics
-Oxidase-positive
-Tolerates 6% NaCl
-Thiosulfate citrate bile salts sucrose (TCBS) agar
-curved bacilli
V. cholerae: pandemics; munches on sucrose (yellow)
V. parahaemolyticus: #1 Vibrio in US (seafood)
V. vulnificus: #1 Vibrio cause of death in US

Heliobacter pylori characteristics
-Screening: serology (IgG)
-Diagnosis: surgical pathology, CLO test, urea breath test
-Test of cure: stool antigen test, urea breath test
-Mega urease-producer (CLO test hot pink)
-can cause gastritis, peptic ulcer disease, gastric cancer, and gastric MALT lymphoma which can be treated with antibiotics

GI pathogens
Salmonella (non-typhoidal and typhi)
Shigella
Campylobacter jejuni
Vibrio
Heliobacter pylori
non-fermentative bacilli
Pseudomonas aeruginosa
Stenotrophomonas maltophilia
Acinetobacter
Pseudomonas aeruginosa reservoir
Broad range of habitats
Most grow as biofilms on surfaces
Pseudomonas aeruginosa virulence
LPS, exotoxin, biofilm
Transform to mucoid isolates (CF patients)
Survive with minimal nutrients
Pseudomonas aeruginosa diseases
Invasive disease in neutropenic patients
Ventilator-associated pneumonia
Burn and diabetic wounds
Otitis externa (swimmer’s ear)
Keratitis
Pseudomonas aeruginosa growth
Can be B-hemolytic
Can be mucoid
Can be metallic
Grow on blood, chocolate, MacConkey
Grape Kool-Aid odor
Maybe corn tortilla chips
Pseudomonas aeruginosa identification
Oxidase-positive
Indole-negative
Grows at 42C
Stenotrophomonas maltophilia reservoir
Environment (soil and water - problematic for hospitals)
Stenotrophomonas maltophilia virulence
Opportunist
Risk factors for S. maltophilia mortality:
-ICU
-age >40
-pulmonary source
-resistance to anti-Pseudomonas therapeutic options
Stenotrophomonas maltophilia diseases
Trauma secondary to farm accidents
Immunocompromised and ventilator patients in ICU
Neutropenic patients
Bacteremia
#2 in CF pneumonia
Stenotrophomonas maltophilia growth
Yellow pigment
Grow on blood, chocolate, MacConkey
Odor - grandma's basement
Stenotrophomonas maltophilia identification
Oxidase-negative
Acid from oxidative utilization of maltose, glucose
DNAse-positive
Biochemical battery
Acinetobacter reservoir
Soil and water, sewage, food
Human specimens
Acinetobacter virulence
Can form biofilms
Many strains are highly resistant to antimicrobial agents
Acinetobacter diseases
Colonization believed to occur more than disease
A baumannii complex:
-VAP, BSI with high morbidity and mortality in ICU
-Iraqibacter (skin and soft tissue infections)
Acinetobacter growth
Non-motile "A-cineto"
Growth on blood, chocolate, MacConkey

Acinetobacter identification
Oxidase negative
Biochemical profiling
Non-glucose fermenter
Fastidious bacteria
Legionella pneumophila
Bordetella pertussis
Chlamydia trachomatis
Chlamydia pneumoniae
Chlamydia psittaci
Mollicutes
Legionella pneumophila reservoir
Natural bodies of water
Higher concentrations in stagnant water
Symbiosis and multiplication within amoeba
Legionella pneumophila virulence
Infection acquired by aerosol inhalation of contaminated water
Infects macrophages and resides in phagosomes
Affect host cell death and release of organisms
Legionella pneumophila diseases
Unusual case of pneumonia (10,000 to 20,000 in US)
Underestimated incidence
Risk factors:
-suppression of CMI
-smoking
-corticosteroids
Legionella pneumophila growth
Specimen treatment to reduce contaminants
Growth on Buffered Charcoal Yeast Extract (BCYE)
No growth on blood
Carbolfuchsin counterstain
We’re bad at growing this
Legionella pneumophila identification
Ground glass (opal-like) colonies
Suspect colonies are subculture to BCYE and blood
Urine antigen testing in severe illness
Stains faintly
Bordetella pertussis reservoir
Humans (carry)
Kids often get it from patents
Teenagers (due for boosters)
Bordetella pertussis virulence
ID: 100 organisms (low!!)
90% transmission rate to susceptible hosts
Toxin destroys cells of mucociliary escalator (hard for cells to regenerate: takes a while)
“100-day cough”
Bordetella pertussis diseases
Pertussis (vaccine-preventable illness; runs in 2–5-year cycles)
Three Stages of Pertussis:
Catarrhal phase (runny nose, sneezing, cough)
Paroxysmal phase (spasmodic cough/whoop, post-tussive vomiting)
Convalescent phase (may last months)
Bordetella pertussis growth
Must use nasopharyngeal swab
Cultivation on Bordet-Gengou; Regan-Lowe
Bordetella pertussis identification
Molecular diagnostics in test of choice
May try to culture for typing/epidemiology studies
Chlamydia trachomatis reservoir
Humans
(More common STD than gonorrhea)
Chlamydia trachomatis virulence
“wedding crasher”
Drives its own replication and release (reticulate, elementary bodies) and its own protection (persistence in means of evading immunity)
Chlamydia trachomatis diseases
Diseases based on 18 different MOMPs:
4 MOMPs: trachoma (blindness)
10 MOMPs: genital (cervicitis, urethritis, PID, endometritis, salpingitis, epididymitis)
4 MOMPs: lymphogranuloma venereum (ulcerative form; systemic STD)
Chlamydia trachomatis growth
Old: cell cultures (host cells) with mAb; staining of CPE: cytopathic effect
-takes a while, expensive
Now: shell vial culture with "blind" mAb staining
-takes 2 days
Chlamydia trachomatis identification
Molecular diagnostics (look for nametags)
Chlamydia pneumoniae reservoir
humans
Chlamydia pneumoniae virulence
Associated with community-acquired pneumonia (10-15%)
Symptoms non-specific (like virus)
Chlamydia pneumoniae diseases
Shell vial culture
Serology should be acute and convalescent (due to seroprevalence)
Molecular not ready for prime time
Chlamydia psittaci reservoir
Psittacine birds (parrots)
Poultry (ducks, turkeys)
Chlamydia psittaci virulence
Infectious forms shed: remain viable for months
Inhalation of aerosols
Direct contact with infected bird, fecal, or feather dust
Chlamydia psittaci diseases
Mild illness to severe pneumonia
Endocarditis
10 in US per year
Practice hygiene and quarantine birds
Mollicutes characteristics
Smallest free-living microbes capable of replication
Small genome
no cell wall
tri-layer cell membrane, making it not sucesptible to many antibiotics
Mollicutes diseases
M. pneumoniae: walking pneumonia
M. genitalium: STD
Mollicutes growth
Don't grow on blood
Very SLOW growers
Serology can be cross-reactive between species